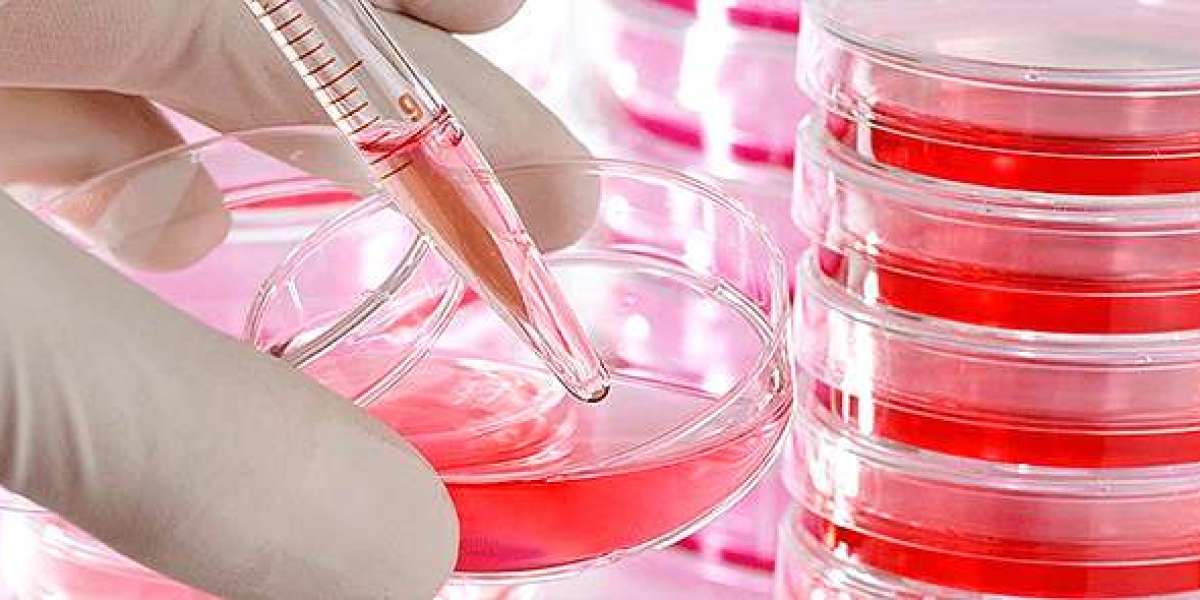

In the pursuit for glowing, vivid skin, a number of us transform to topical therapies and strenuous skin care routines, often ignoring the foundational function that vitamins and supplements play in our skin's wellness. The skin, our body's biggest body organ, is a representation of our total health. It's not just regarding what we placed on our skin however additionally regarding what we feed our body. Vitamins and supplements can supply the essential nutrients our skin requires to flourish, working as the building obstructs click here for more information a radiant skin tone. By recognizing the basics of skin health and wellness vitamins and supplements, we can unlock the secret to not only looking our finest but also feeling our best.

The journey to glowing skin starts with Vitamin A, a powerhouse in the globe of skin care. Typically found in retinol kind in topical therapies, Vitamin A is vital for skin repair and maintenance. When ingested, it helps in the production of new skin cells and can decrease the appearance of great lines and creases by boosting collagen production. However Vitamin A does not function alone; it's component of a group. Vitamin C, an antioxidant recognized for its role in immune feature, also plays a crucial component in the manufacturing of collagen, helping in skin elasticity and brightness. It helps ward off the signs of aging and can secure the skin from the damage triggered by complimentary radicals and sun direct exposure. Furthermore, Vitamin C's capacity to decrease melanin manufacturing makes it a useful ally in the battle versus hyperpigmentation and dark spots.
After that there's Vitamin E, one more anti-oxidant that operates in tandem with Vitamin C, improving its efficiency and assisting to safeguard the skin from ecological stress factors like pollution and UV damages. Vitamin E is especially known for its moisturizing properties, making it a staple in the management of completely dry skin. Its ability to assist repair the skin barrier is crucial for preserving hydration and safeguarding against irritants. Additionally, for those having problem with swelling or acne, Zinc serves as a knight in beaming shield. This mineral helps to minimize inflammation and germs production, which prevail offenders behind acne breakouts. Zinc likewise plays a role in skin healing and regeneration, guaranteeing that the skin can recoup from damage a lot more effectively.
Allow's not neglect regarding Omega-3 fatty acids, which could be more famous for their heart health benefits but are equally essential for skin health and wellness. Omega-3s located in fish oil supplements can greatly influence the skin by maintaining its lipid barrier, which is crucial for keeping the skin plump and hydrated. These fats likewise possess anti-inflammatory properties, aiding to calm problems like eczema, psoriasis, click here for more information and acne. By including a fish oil supplement right into your routine, you're not simply doing your heart a favor however likewise nurturing your skin from the within out.
Navigating the globe of supplements and vitamins can be challenging, however understanding the specific benefits they use makes it much easier to customize a program that supports your skin's unique demands. It's important to bear in mind that while supplements can offer a considerable increase to your skin health and wellness, they work best in conjunction with a balanced diet, sufficient hydration, and click here for more information a consistent skincare regimen. It's additionally a good idea to seek advice from a medical care expert before starting any brand-new supplement, particularly if you have underlying health and wellness conditions or are pregnant.
In final thought, the path to glowing, healthy and balanced skin is diverse. It's not practically the lotions and lotions we apply yet additionally regarding supporting our skin from the within out with the best vitamins and supplements. By providing our bodies with the nutrients it requires, we can enhance our skin's all-natural capability to fix, regrow, and stand up to the signs of aging. So, the next time you examine your skincare routine, consider including a few important vitamins and supplements to your toolbox. Your skin, after all, is a mirror of your general health, and by taking care of it from within, you're setting the phase click here for more information lasting appeal and vigor.
In the quest for glowing, vibrant skin, numerous of us turn to topical therapies and rigorous skin care routines, typically forgeting the foundational function that vitamins and supplements play in our skin's health. By comprehending the fundamentals of skin wellness vitamins and supplements, we can unlock the trick to not only looking our finest however additionally feeling our best.
There's Vitamin E, an additional anti-oxidant that works in tandem with Vitamin C, boosting its performance and helping to shield the skin from ecological stressors like pollution and UV damage. Zinc likewise plays a function in skin recovery and regrowth, making sure that the skin can recoup from damage more successfully.
Omega-3s discovered in fish oil supplements can greatly affect the skin by preserving its lipid barrier, which is crucial for keeping the skin hydrated and plump.